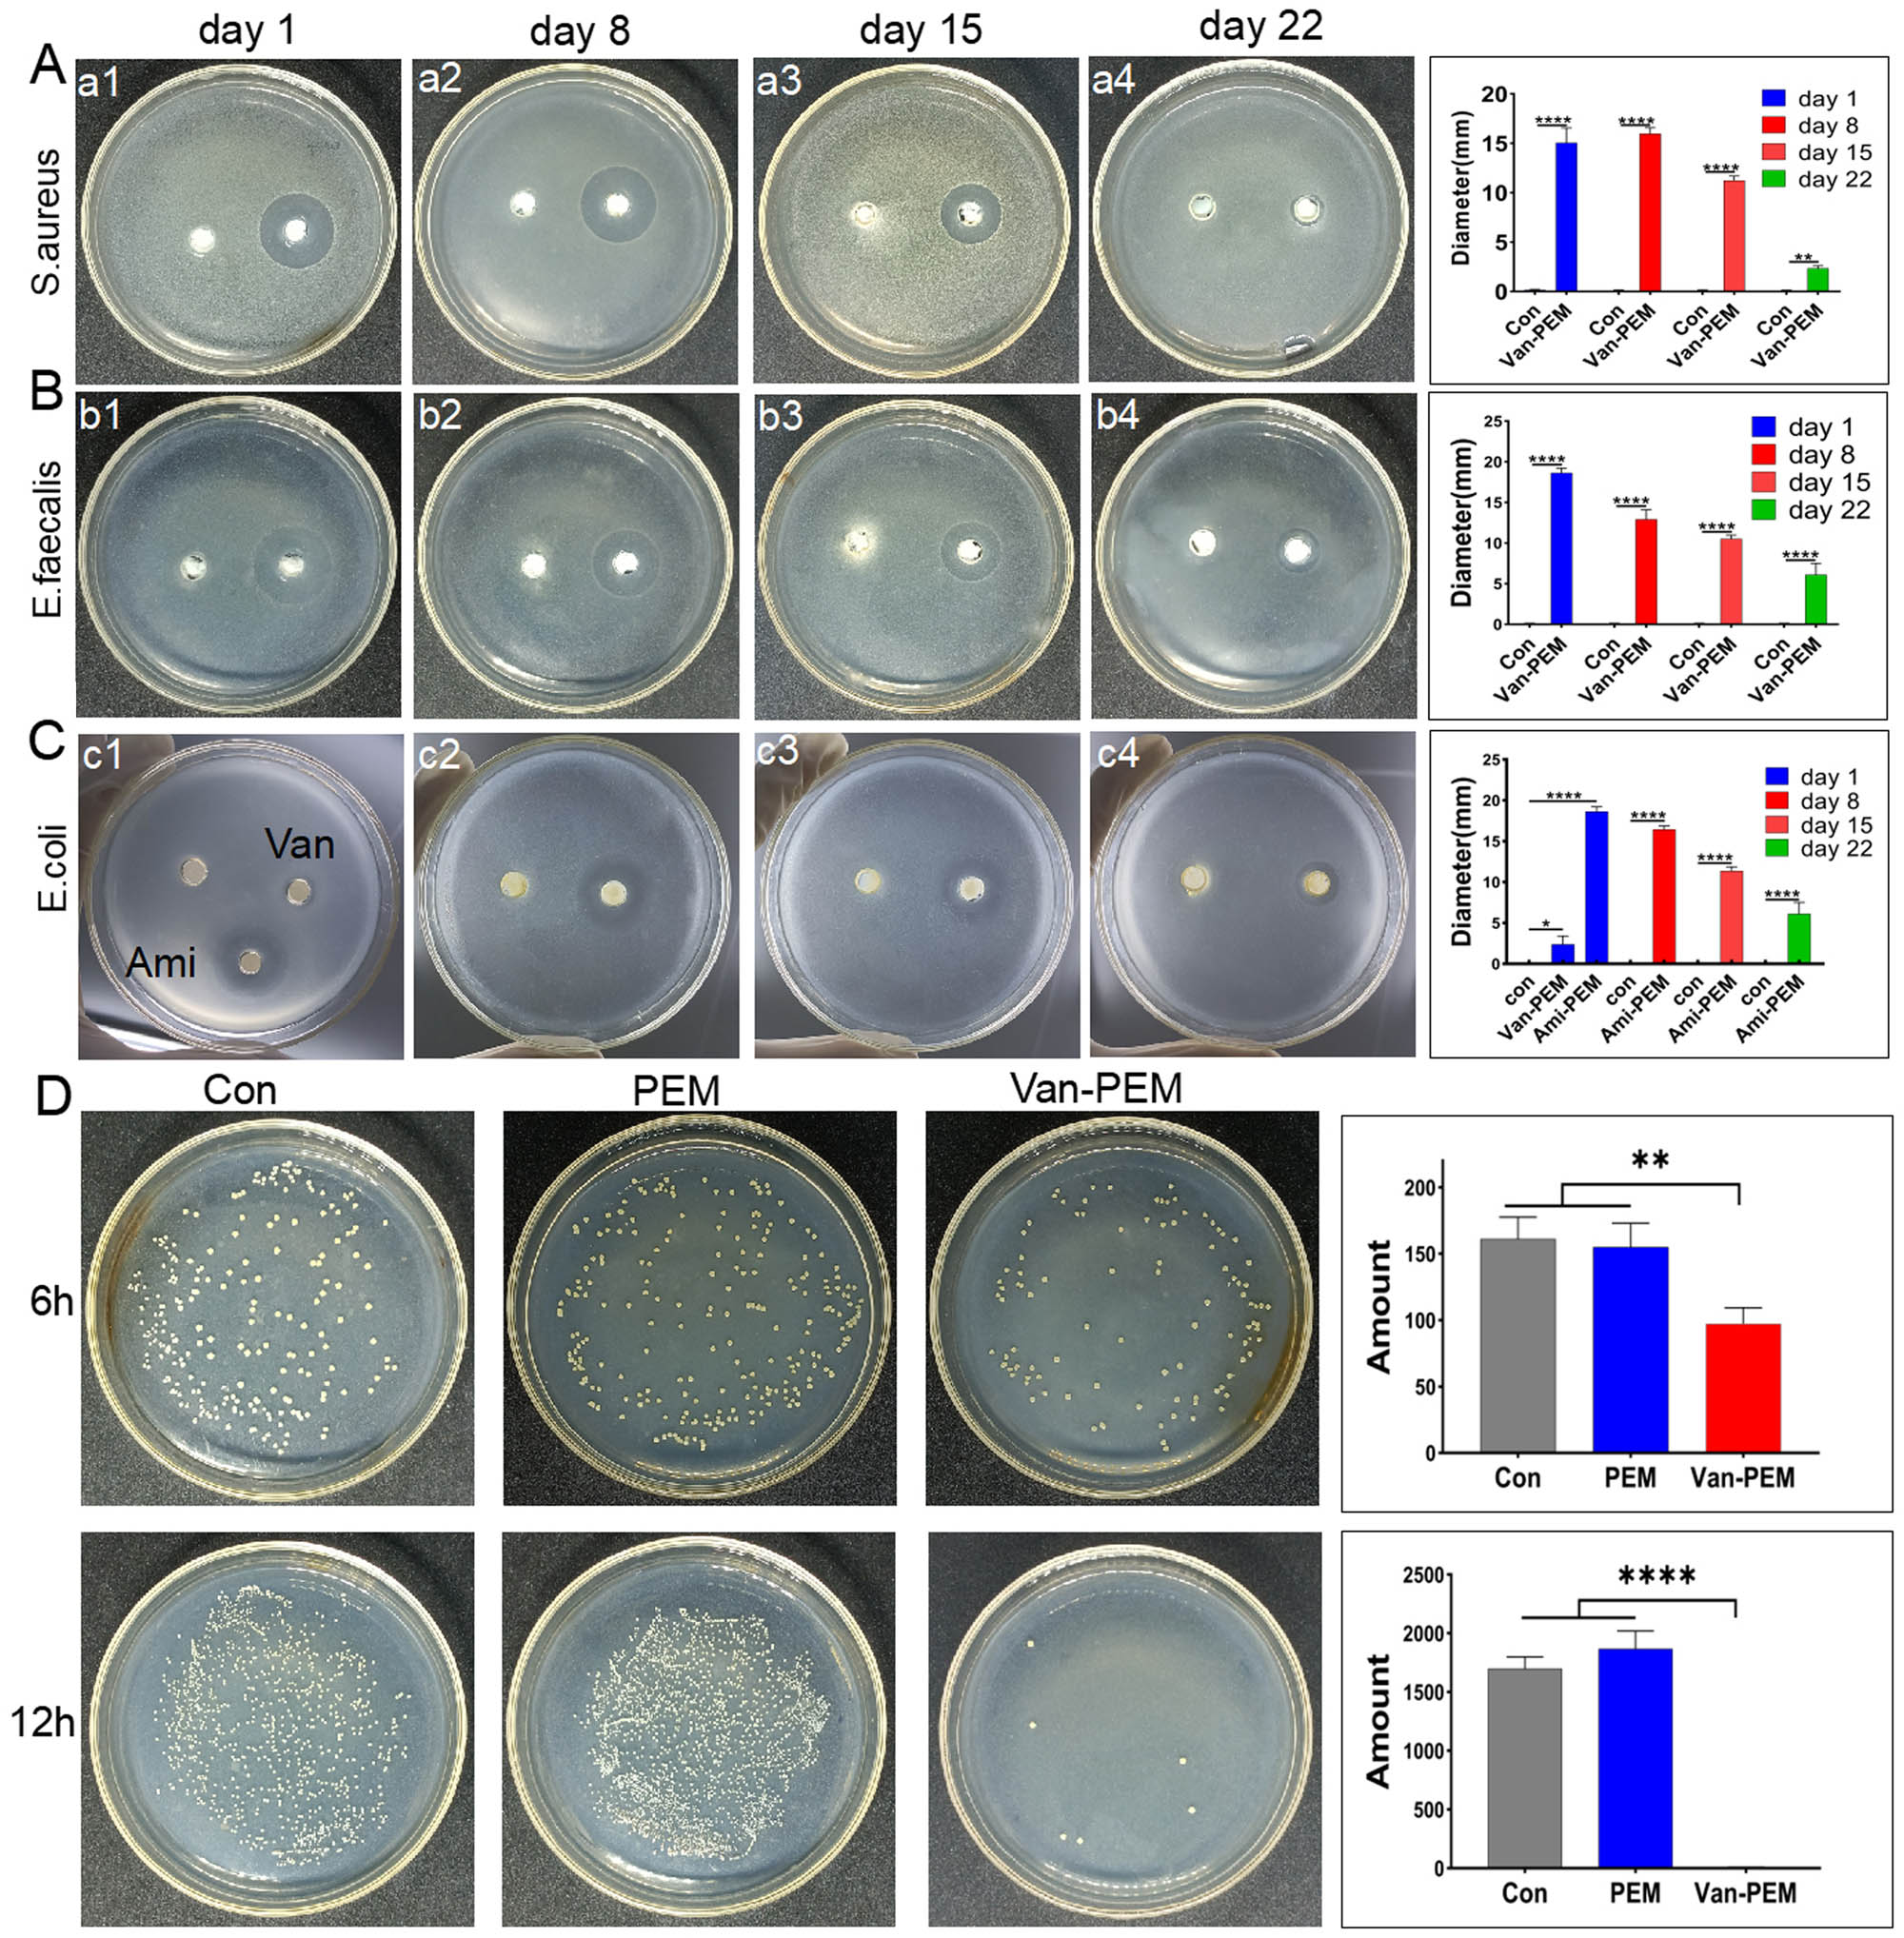
Figure 4 
                  (a and b) Bacteriostasis of the Van-PEM hydrogel against S. aureus and Enterococcus on days 1, 8, 15, and 22. It was demonstrated that Van-PEM hydrogel was still able to kill gram-positive bacteria on day 22. (c) Bacteriostasis of the Ami-PEM hydrogel against E. coli on days 1, 8, 15, and 22. (d) Bacterioplankton killing abilities of the PEM and Van-PEM hydrogels.

Abstract
The treatment of infectious bone defects has become a troublesome issue in orthopedics. The disease requires effective anti-infective and bone-reconstruction therapeutic functionalities. In this study, we prepared a novel antibacterial material (vancomycin-impregnated periosteal extracellular matrix [Van-PEM]) by embedding vancomycin in a periosteal extracellular matrix (PEM)-derived hydrogel via physical stirring for the treatment of infectious bone defects. The microstructure, porosity, degradation, and release properties of this antibacterial hydrogel were characterized. The in vitro hemolytic reaction, cytotoxicity, osteogenic ability, and antibacterial properties were also carefully studied. The results showed that the Van-PEM hydrogel possessed a fibrous network structure with high porosity. Moreover, the hydrogel demonstrated slow degradation in vitro and could release vancomycin for at least 1 week. The hydrogel showed no cytotoxicity and possessed good biocompatibility with blood cells. It also promoted osteogenesis and exerted a significant bactericidal effect. Subsequently, the anti-infection and bone-healing abilities of the antibacterial hydrogel were investigated in a rat model of infectious calvarial defects, and the infectious skull defect was successfully cured in vivo. Therefore, Van-PEM hydrogels may represent a promising therapeutic approach for treating infectious bone defects.
Abbreviations
- ALP
-
alkaline phosphatase
- ANOVA
-
analysis of variance
- BMSCs
-
bone marrow mesenchymal stem cells
- CCK-8
-
cell counting kit-8
- CCM
-
colony count method
- DAPI
-
4′,6-diamino-2-phenylindole staining
- DMEM
-
Dulbecco’s modified Eagle’s medium
- EDS
-
energy-dispersive X-ray spectroscopy
- FTIR
-
Fourier transform infrared spectra
- GAPDH
-
glyceraldehyde-3-phosphate dehydrogenase
- H&E
-
hematoxylin and eosin staining
- MRSA
-
methicillin-resistant Staphylococcus aureus
- OCM
-
Oxford cup method
- OD
-
optical density
- PBS
-
phosphate-buffered saline
- PEM
-
periosteal extracellular matrix
- qPCR
-
quantitative polymerase chain reaction
- SEM
-
scanning electron microscopy
- TBS
-
tris-buffered saline
- Van-PEM
-
vancomycin-impregnated periosteal extracellular matrix
1 Introduction
Infectious bone defects caused by osteomyelitis and open fracture infections are difficult to heal [1,2]. Staphylococcus aureus is the most common causative agent of bone infections [3]. Although bone tissue possesses remarkable regeneration and repair capabilities, when infections and bone defects reach a critical size, a bone repair can no longer proceed spontaneously [4]. Bone transplantation is the most commonly used technique for repairing bone defects. This technique repairs bone defects through the formation of new bone and the degradation of the transplanted bone (crawling replacement process). The key to the success of bone transplantation lies in a sterile and well-vascularized host bed. Orthopedic surgeons typically use repeated debridement and prolonged systemic antibiotic therapy to control bone defect wound infections [5,6]. In recent years, the local use of antibiotics has become a hot topic in the treatment of bone infections because this technique can maintain an effective antibacterial concentration while reducing antibiotic resistance and systemic toxicity. The usage of topical antibiotic-carrying cement with systemic antibiotics has become the main treatment strategy for bone infectious defects. Recently, biodegradable bone substitutes have been used to provide local antibacterial and osteogenic effects [7], with the expectation of a shift from multi-stage treatment to single-stage treatment.
Biodegradable bone substitutes, including bioactive glass, hydroxyapatite, and tricalcium phosphate, have been the focus of several studies [8,9,10,11,12]. Anti-microbial agents can be loaded into bone substitutes using various methods, including electrostatic adsorption, porous physical adsorption, nano-encapsulation, microsphere encapsulation, and chemical cross-linking [8,11,12,13,14]. Currently, antibiotics and metallic nanosilver are the most commonly used antimicrobials [15] to achieve antibacterial activity. However, several challenges remain. First, most bone substitutes require surface modification before binding to antibacterial agents, often with toxic crosslinking agents such as glutaraldehyde [8]. Second, bone substitutes must be capable of both bone induction and conduction [16]. Currently, most bone substitutes are non-bioactive materials, and the bone induction and conduction effects are usually much lower than those of bioactive bone substitutes and may be weakened in an infected environment [5]. Finally, Ag is cytotoxic and is not conducive to tissue repair and osteogenesis. In addition, its accumulation in the body may increase the burden on the liver and kidneys [11].
Bioactive materials, especially type I collagen, which is a major component of the bone extracellular matrix, have been studied as bone substitutes because of their unparalleled biocompatibility with non-biomaterials and their ability to simulate the cellular microenvironment and stimulate and support cell proliferation [17]. Tissue cell matrix material that retains the natural internal three-dimensional framework, a large number of protein structures, growth factors, and other active ingredients can retain the native microenvironment of the cell to a great extent and maintain its original features, leading to cell adhesion, proliferation, and differentiation along with promoting tissue repair and regeneration. These advantages cannot be achieved using the current synthetic materials [18]. This three-dimensional structure can also provide bone conduction to host capillaries and bone progenitor cells [6]. Cellular tissue-derived hydrogels can also retain complex biochemical components and assemble to form nanofibrous scaffolds. These scaffolds can recruit surrounding cells to migrate to the scaffolds, attach to the collagen fibers within the scaffolds, grow in parallel, and then replace by regenerative tissue [19,20,21].
The periosteum is a connective tissue envelope covering the surface of the bone and contains many growth factors, such as BMP-2, IGF-1, and TGF-β. These factors have strong bone induction abilities and play a critical role in the bone repair process [22]. In addition, the periosteum is rich in collagen, which promotes osteoblast differentiation and formation of mineralized nodules [23], which is the basic structural unit of natural bone [24]. It has been demonstrated that acellular periosteum scaffolds can promote bone defect regeneration and ectopic ossification [25,26,27]. In our previous study, we decellularized the periosteum and prepared it into a hydrogel, which could enhance osteogenesis, osteogenic differentiation, and biological bone mineralization, thus making it suitable for bone defect repair [28]. Antibiotics can be soaked and physically embedded in collagen hydrogels for functional applications [29,30]. However, the effect of vancomycin-loaded extracellular matrix hydrogels on the repair of infectious bone defects requires further investigation.
In this study, vancomycin was physically encapsulated in an acellular perichondrium hydrogel to prepare a novel material with antibacterial and osteogenic properties (Scheme 1). Since the filamentous collagen fibers that make up the gel had the characteristics of micro–nanostructure, the porous structure composed of them was more in favor of drug loading. The vancomycin-impregnated periosteal extracellular matrix (Van-PEM) hydrogel exhibited satisfactory long-acting bactericidal, biocompatible, and osteogenic properties. The antibacterial and bone-healing abilities of the Van-PEM hydrogel were verified in vitro and in vivo, suggesting that the Van-PEM hydrogel possesses potential as an antibacterial bone substitute for use in treating infectious bone defects.

Schematic showing application of the porcine-acellular-periosteal-matrix hydrogel-encapsulated vancomycin to heal infectious bone defects.
2 Materials and methods
2.1 Materials
Triton X-100 solution and sodium dodecyl sulfate were purchased from Sinopharm Chemical Reagents Co., Ltd. Giemsa stain, pepsin, and Masson’s trichrome staining kits were purchased from Beijing Solarbio Science & Technology Co., Ltd. Alkaline phosphatase (ALP) assay kit was purchased from Nanjing Jiancheng Bioengineering Institute Co., Ltd. Lutein was purchased from Yeasen Biotech Co., Ltd.
2.2 Synthesis of the Van-PEM hydrogel
The periosteum was removed from the femur surface of an adult pig sourced from a local abattoir. Three freeze–thaw cycles (−80 to 37°C) were performed after removing the stains on the periosteum surface; then, the periosteum was cut into appropriate size after removing other tissues on the surface with scissors. The periosteum was placed in a 1% Triton solution, and the rotation speed was adjusted to 120 rpm for 12 h, then placed in a 1% sodium dodecyl sulfate solution at the same speed for 2 h, and rinsed with flowing phosphate-buffered saline (PBS) buffer for 12 h. The tissue was ground into a powder after freeze–drying overnight, and 20 mg/mL periosteum powder was slowly added to the solution containing pepsin and vigorously stirred, and the pH of the solution was adjusted to approximately 1.5. Vancomycin was added to the solution and stirred evenly to achieve a concentration of 2 mg/mL vancomycin. The solution was digested on a shaking table for 2 h until the periosteum powder was fully dissolved. The solution was stored at 4°C for 2 weeks. For use, 10× PBS solution and sodium hydroxide solutions were added to adjust the pH to 7–8. The solid hydrogel was prepared after the solution was incubated at 37°C for approximately 5 min.
2.3 Porosity
Two methods were used to measure the porosities of the PEM and Van-PEM hydrogels. The first method was the medium-immersion method. After the hydrogel was placed at −80°C for 1 h, it was freeze-dried overnight. We weighed (W 1) the freeze-dried hydrogel, saturated it with isopropyl alcohol, removed the lyophilized gel, wiped the isopropyl alcohol from the surface, and reweighed the sample (W 2). An appropriate volume of isopropyl alcohol (V 1) was added to a calibrated test tube, soaked lyophilized gel was gently added to the test tube, and the volume (V 2) was recorded. The porosity was calculated as follows:
where ρ is the density of isopropyl alcohol. The second method used to measure the porosity was to scan the sample section with scanning electron microscopy (SEM) and calculate the gel porosity using ImageJ software.
2.4 In vitro degradation performance
The PEM and Van-PEM hydrogels were weighed and placed in a solution containing collagenase I (5 U/mL) for 21 days at 37°C. The enzyme solution was changed every 3 days. Samples were weighed for degradation at 7, 14, and 21 days. The samples were washed with PBS before weighing to remove enzyme solution. The remaining mass after degradation was quantified by dividing the weight degraded by the original weight. The degradation of PEM and Van-PEM hydrogels in PBS without collagen protease I was tested using the aforementioned method. The PBS solution containing collagen protease I was replaced with the PBS solution, and the degradation of PEM and Van-PEM hydrogels was tested again as described above. Finally, the pH of the PBS solution was adjusted to 5, and the aforementioned steps were repeated to test the degradation of the PEM and Van-PEM hydrogels in an acidic PBS solution.
2.5 Release of vancomycin from the Van-PEM hydrogel
To determine the release of vancomycin, a series of vancomycin solutions with varying concentrations was prepared, and the absorbance values were measured using a UV spectrophotometer to create a standard curve (Y = 1.8068x + 0.1092, R 2 = 0.996). Then, the PEM and Van-PEM hydrogels were placed in centrifuge tubes, 1 mL of PBS solution was added, and the tubes were placed in a 37°C thermostat. PBS solution was removed at specific time intervals. After the dissolved hydrogel was removed by centrifugation, a release curve was constructed from the optical density (OD) measured at 281 nm. The release behavior of PEM hydrogels containing 1, 4, and 7 mg/mL vancomycin was tested in a PBS solution. In addition, the release performance of PEM hydrogels containing 2 mg/mL vancomycin was investigated in PBS, PBS containing collagen protease I, and acidic PBS.
2.6 Antibacterial properties in vitro
The antibacterial properties of the Van-PEM hydrogels were determined using the Oxford cup method (OCM). Representative gram-positive (S. aureus and Enterococcus faecalis) and gram-negative bacteria (Escherichia coli) were selected for the experiment. First, a single colony of bacteria was placed in a test tube containing a liquid medium, and the test tube was placed in a shaker with a speed of 150 rpm and a temperature of 37°C overnight. A certain volume of bacteria in the test tube was selected and diluted until the OD value was 0.1 (0–1.5 × 108 UFC/L). The bacteria and medium (50–60°C) were thoroughly mixed and added to a Petri dish, where the volume ratio of bacteria and medium was 1:10. When the medium cooled and became solid, an Oxford cup was used to make two identical wells in the medium, and the same volume of PEM and Van-PEM hydrogels was added to the wells, and the Petri dishes were placed in the bacterial incubator. The diameter of the sterile circle around the hydrogel was measured and recorded after 12 h. The antibacterial effects of the PEM and Van-PEM hydrogels soaked in PBS for 7, 14, and 21 days were also tested using the aforementioned method.
Subsequently, S. aureus was used for colony count method (CCM) detection. First, the PEM and Van-PEM hydrogels were cut into small pieces, placed in test tubes, and sterilized under UV light for 6 h. After adding the same volume of medium containing S. aureus (108 UFC/L) to the test tube, the test tube was placed on a shaker, and the conditions were set as described above. At 6 and 12 h, 20 µL of bacterial suspensions of the same ratio was removed and incubated on a nutrient agar plate at 37°C for 24 h, after which the bacteria on the plate were counted.
2.7 Cytotoxicity and hemolysis test
Hundred microliters of PEM hydrogel and Van-PEM hydrogel were added to a 24-well plate for irradiation (25 kg, γ-radiation) sterilization. Bone marrow mesenchymal stem cells (BMSCs) were seeded in the empty wells, and wells with PEM hydrogels, and Van-PEM hydrogels at a density of 4 × 104 cells/hole. Dulbecco’s modified Eagle’s medium (DMEM; Hyclone) containing 10% (v/v) fetal bovine serum, 100 μg/mL penicillin, and 100 μg/mL streptomycin was added to the culture wells. The cells were cultured at 37°C in a humid environment containing 5% carbon dioxide. After co-culturing for 48 h, the cells were stained with calophyllum staining kit for living cells and observed under a fluorescence microscope at 515 nm wavelength.
Cell counting kit-8 (CCK8) was used to detect the cytotoxicity of the PEM and Van-PEM hydrogels. PEM and Van-PEM hydrogels were soaked in DMEM (the volume of hydrogel/the volume of culture medium is 1:5), the supernatant as 100% leaching solution was collected, and then mixed with a proportion of DMEM cell culture to obtain the culture solution containing 0, 20, 50, and 100% leaching solution for further experiments. Mesenchymal stem cells (MSCs) were inoculated into 96-well plates at a density of 2,000 cells per well. After incubation at 37°C for 24 h, the supernatant medium was removed from each well, 100 μL of medium containing different proportions of leachate was added, and DMEM without leachate was used as a control group. On days 1, 3, and 5, respectively, 10 μL of DMEM cell culture containing CCK8 reagent was added to each well and incubated at 37°C for 1 h, then measured with a spectrophotometer at 450 nm wavelength.
Hemolysis of the PEM and Van-PEM hydrogels was evaluated using a previously reported method [31]. One milliliter of blood collected from volunteers was added to a sterile Eppendorf tube and centrifuged at 850g for 5 min. The supernatant was discarded, and the red blood cells were rinsed several times with isotonic sterile PBS solution. The rinsed red blood cells were then suspended in Eppendorf tubes containing deionized water and PBS. PEM and Van-PEM hydrogels were added to the erythrocyte suspension, incubated at 37°C for 60 min, and centrifuged for 5 min. The absorbance of the supernatant was measured at 540 nm, and the hemolysis rate was calculated. Eppendorf tubes containing deionized water were used as positive controls, and Eppendorf tubes containing PBS were used as negative controls. The percentage of hemolysis was calculated using the following formula: (OD of sample − OD of negative control)/OD of positive control × 100.
2.8 Osteogenesis tests
The ALP activity of the MC3T3-E1 cells was monitored using an ALP assay kit. The PEM and Van-PEM hydrogels were irradiated after being placed in a 24-well plate. MC3T3-E1 cells were seeded in 20 mg/mL PEM and Van-PEM hydrogels. The cells were first incubated in DMEM for 24 h and then replaced with osteoblast induction medium, which included 100 nM dexamethasone, 5 μM ascorbic acid, and 1 mM B-glycerophosphate. On days 3 and 7, the ALP activity of MC3T3-E1 cells in different samples was measured according to the manufacturer’s instructions.
ALP staining was used to detect ALP expression. MC3T3-E1 cells (1 × 105) were placed in 24-well plates containing PEM and Van-PEM hydrogels. The osteoblast induction medium was changed every 2 days and incubated at 37°C for 7 days for staining. The samples were lightly cleaned three times with Tris-buffered saline (TBS) solution and fixed with 4% paraformaldehyde at 37°C. An ALP staining kit was used for staining and observation after 12 h.
Quantitative polymerase chain reaction (qPCR) analysis was used to detect the expression of genes related to osteogenesis. MC3T3-E1 cells were seeded in 24-well plates containing 20 mg/mL PEM hydrogel or Van-PEM hydrogel at a density of 1 × 105 cells/well. Wells lacking hydrogel substrates were used as negative controls. qPCR was performed on day 14 for Runx2, OSX, and OCN. The cells were then stained with ALP. PCR was performed using the standard method for each target gene, standardized by glyceraldehyde-3-phosphate dehydrogenase (GAPDH), and calculated using the 2−ΔΔCt method. Primer sequences for each gene are listed in Table S1.
2.9 In vivo experiments
2.9.1 Model of infectious bone defects
Male SD rats weighing 200–300 g were selected for animal experiments. All animal experiments were approved by the Institutional Animal Care and Use Committee (IACUC) of the Zhejiang Center of Laboratory Animals (ZJCLA). The following procedure was used to create infectious bone defects in rat skulls. After the rats were completely anesthetized, hair on the surface of the skull was removed using a shaving machine, and the skin was disinfected with 75% alcohol. The skull was exposed after the skin was cut, and a 4 mm-diameter defect was created in the middle of the skull by turning the head [32]. The head was continuously immersed in sterile saline during the surgery. The defect site was soaked in 100 µL of methicillin-resistant S. aureus (MRSA) at 108 CFU/mL, after which collagen plugs were resorbed (REF 260-509-400, Bicon, USA) to cover each defect and create an infectious bone defect model. The experimental rats were divided into three groups with four rats in each group. In the first group, no bacteria or hydrogel was added to the skull defect, whereas in the second group, only MRSA was added to the skull defect; in the third group, MRSA and the prefabricated gel with a diameter of 4 mm and a height of 3 mm were added to the skull defect. Absorbable sutures were used to suture the cranial membrane and skin.
2.9.2 In vivo sterilization evaluation
The skull was collected 1 week after surgery and scanned using micro-CT (Hiscan XM) to observe the preparation of the bone infection model. At Weeks 5 and 9, 2 mm × 1 mm tissue was cut from the skull defects of rats. The samples were placed in normal saline and stirred for 10 min. Twenty microliters of the above mixture were absorbed and inoculated onto a bacterial Petri dish. After the dishes were placed in a bacterial incubator for 24 h, the number of colonies on the dishes was observed and recorded.
2.9.3 Evaluation of osteogenic ability in vivo
At 5 and 9 weeks postoperative, the bone was extracted and scanned with a micro-CT 25 μm scanner to observe the erosion of the skull surface. ImageJ was used to calculate the bone defect area of the micro-CT scanning image to judge the erosion of the skull by bacteria and the formation of new bone. Bone infection was assessed using H&E and Giemsa staining, and bone fiber regeneration was assessed using Masson staining.
3 Results and discussion
3.1 Preparation and characterization of the vancomycin-embedded acellular periosteum Van-PEM hydrogel
A hydrogel derived from a decellularized periosteum matrix was prepared, and its microstructure and composition were characterized. In addition, bond formation between vancomycin and the hydrogel was assayed. After decellularization, no marked changes in the periosteal tension were observed (Figure 1a). At the same time, it was observed that the vancomycin-loaded hydrogels exhibited flow dynamics under acidic conditions during the preparation process and could be transformed into uniform gel (solid) state after incubation for 5 min at neutral temperature and 37°C (Figure 1b). The DNA content within the periosteum was almost undetectable (native groups vs decellularized groups: 296.7 ± 20.82 ng/mg wet weight vs 5.00 ± 2.00, p < 0.05, Figure 1c). H&E staining results indicated that the periosteum still possessed a well-organized cambium and fibrous layer structure after cell removal (Figure 1d), which was also confirmed by 4′,6-diamino-2-phenylindole staining (DAPI) staining (Figure 1e). These results demonstrate that the structure of the extracellular matrix of the periosteum was preserved after decellularization, which may benefit the preservation of function [30]. The Fourier transform infrared spectra (FTIR) spectra of the PEM and Van-PEM hydrogels showed that the functional groups mainly included OH/NH stretching at 3,300 cm−1, C═N stretching at 1,550 cm−1, C═C stretching at 1,640 cm−1, and C–H stretching at 2,924 cm−1, while the peaks at 1,400 and 1,450 cm−1 corresponded to C–H bending, and the peak at 1,070 cm−1 was attributed to C–O stretching [33]. The addition of vancomycin did not alter the absorption peak of the PEM hydrogel (Figure 1f). This indicated that vancomycin was simply embedded in the hydrogel without any reaction between it and the hydrogel to generate new chemical bonds.

(a) Primary and post-acellular periosteum. (b) Pregel solution under acidic conditions and solid gel under neutral conditions. (c) Changes in the DNA content before and after the acellular process. DNA tests confirmed the removal of the nucleus. (d) H&E staining before and after periosteum decellularization confirms the complete removal of cells (red dashed circles) and the preservation of collagen fibers (black dashed circles). (e) DAPI staining before and after the acellular process. DAPI staining demonstrated that the periosteum was completely removed after acellular treatment. (f) FTIR spectra of the PEM and Van-PEM hydrogels, and it was confirmed that the addition of vancomycin did not react with PEM hydrogel to generate new chemical bonds.
Representative microstructures of the PEM and Van-PEM hydrogels were observed using SEM. The results show that the microstructures of the PEM and Van-PEM hydrogels were three-dimensional nanofiber network (Figure 2a and b). The porosity was calculated using ImageJ software (Figure 2ab1 and bd1), and the PEM hydrogel and Van-PEM hydrogels possessed similar porosities (PEM hydrogel groups vs Van-PEM hydrogel groups: 46.52 ± 3.715% vs 43.38 ± 2.957%, p > 0.05, Figure 2c), indicating that the addition of vancomycin did not significantly change the porosity of PEM hydrogel. Thus, vancomycin may be embedded in the fiber structure instead of the fiber interstitium. The energy-dispersive X-ray spectroscopy (EDS) results showed that the PEM and Van-PEM hydrogels were mainly composed of C, N, O, Na, P, S, and Cl, in which P is a necessary element for the formation of hydroxyapatite crystals. It can be deposited in the collagen fibers and the nano-interstices between collagen fibers, thus promoting osteoid mineralization into new bone [34] (Figure 2d).
![Figure 2
[(a) Microstructure of the PEM hydrogel at 5,000× (a) and 10,000× (b); (b1) is the condition of (b) after ImageJ software processing]. [(b) Microstructure of the Van-PEM hydrogel at 5,000× (c) and 10,000× (d); (d1) is the condition of (d) after ImageJ software processing]. (c) Porosities of the PEM and Van-PEM hydrogels calculated by statistical treatment. Meanwhile, the porosities of the PEM and Van-PEM hydrogels exhibited that vancomycin did not significantly change the porosity of PEM hydrogels. (d) EDS analysis of the PEM and Van-PEM hydrogels.](/document/doi/10.1515/ntrev-2022-0524/asset/graphic/j_ntrev-2022-0524_fig_002.jpg)
[(a) Microstructure of the PEM hydrogel at 5,000× (a) and 10,000× (b); (b1) is the condition of (b) after ImageJ software processing]. [(b) Microstructure of the Van-PEM hydrogel at 5,000× (c) and 10,000× (d); (d1) is the condition of (d) after ImageJ software processing]. (c) Porosities of the PEM and Van-PEM hydrogels calculated by statistical treatment. Meanwhile, the porosities of the PEM and Van-PEM hydrogels exhibited that vancomycin did not significantly change the porosity of PEM hydrogels. (d) EDS analysis of the PEM and Van-PEM hydrogels.
The high porosity of the hydrogels can provide sufficient space for the growth of bone progenitor cells and vascular cells and the storage of vancomycin, all of which greatly contribute to bone reconstruction. An image of the PEM hydrogel after freeze–drying is shown in Figure 3a, demonstrating that the periosteum powder formed a scaffold structure through collagen remodeling. The media immersion results showed no significant difference in porosity between the PEM and Van-PEM hydrogel groups (PEM hydrogel groups vs Van-PEM hydrogel groups: 50.96 ± 4.824% vs 53.74 ± 4.048%, p > 0.05, Figure 3b). The porous structure of protein-derived hydrogels is related to the number of viable cells in the hydrogels, and the larger the voids in the hydrogels, the more the cells in the hydrogel can grow [35]. This may be because appropriate porosity allows nutrient exchange between osteoblasts and hosts [36]. The prepared periosteum hydrogel scaffold presented a 3D network structure with appropriate porosity, which provided sufficient space and nutrition for osteoblasts to survive in the scaffold. The collagen fiber structure provides a carrier for hydroxyapatite crystal deposition, thus accelerating bone reconstruction [37].

(a) Morphology of the Van-PEM hydrogel after lyophilization. (b) Porosities of the PEM and Van-PEM hydrogels calculated using the immersion method, proving that the addition of vancomycin did not change the porosity of PEM hydrogel. (c) Degradation of the PEM and Van-PEM hydrogels under neutral and acidic conditions exhibited that PEM and Van-PEM hydrogels under neutral and acidic conditions were slowly degraded, and the acidic conditions would not significantly accelerate the degradation of the hydrogel. (d) Degradation of the PEM and Van-PEM hydrogels in the presence of type I collagen protease. (e) Vancomycin release from the Van-PEM hydrogel loaded with vancomycin at different concentrations. (f) Release of vancomycin from the Van-PEM hydrogel loaded with 2 mg/mL vancomycin under different conditions. The results confirmed that the Van-PEM hydrogel loaded with 2 mg/mL vancomycin demonstrated sustained release behavior under acidic or neutral conditions. The type I collagen protease can accelerate the release of vancomycin in Van-PEM hydrogel.
In the PBS solution, the degradation behaviors of the PEM and Van-PEM hydrogels were similar and slow, and the percentages of residual mass after 21 days were 59.25 ± 1.659 and 64.09 ± 1.899%, respectively (p > 0.05, Figure 3c). It was also observed that the addition of collagen protease accelerated the degradation rate of the PEM and Van-PEM hydrogels, and the PEM and Van-PEM hydrogels were completely degraded after 5 days (Figure 3d). The PEM or Van-PEM scaffolds are clearly fast-degrading scaffolds, especially in the presence of collagenase (5 days). However, despite the degradation of these scaffolds (dECM, fibrin, and collagen), they are playing a crucial role in bone remodeling. In analogy to the bone remodeling after the fracture, such scaffolds are playing an important role in cell attachment and cell migration [38]. In addition, we found that vancomycin was released slowly for at least 21 days. The release behavior was similar; the release rate was fastest within the first 3 days, after which it continued more slowly. After 21 days, the percentages of accumulated released vancomycin were 41.4 ± 4.825% (1 mg/mL), 35.86 ± 2.631% (4 mg/mL), and 30.84 ± 1.429% (7 mg/mL) (Figure 3e). The vancomycin release behavior of the Van-PEM hydrogel in PBS solution at pH 7.5, PBS solution at pH 5, and type I collagenase solution is presented in Figure 3f. The results showed that the release rate of vancomycin was fastest in the type I collagen solution, and the release rate was slow in PBS solutions with pH of 7.5 and 5. This effectively prevents the rapid release of vancomycin, causing the implant to lose its antibacterial effect and become a carrier for bacterial adhesion [39]. Interestingly, when the Van-PEM hydrogel was completely degraded in type I collagenase, the amount of released vancomycin in the solution was 55.07 ± 1.47%, indicating that when the Van-PEM hydrogel was fully degraded, a large portion of vancomycin remained unreleased. This portion of vancomycin may be physically or electrostatically adsorbed onto the surface by hydrogel fragments [7]. As a result, it will not be released into the solution for metabolism, which is conducive to maintaining continuous sterilization and contact sterilization of the hydrogel. This can maintain the sterile state of the hydrogel scaffold and avoid possible side effects caused by high vancomycin concentrations at the same dose [30]. In addition, the infection can lead to a localized acidic environment, which may accelerate implant degradation, increase osteoclast activity, and decrease osteoblast activity, thereby impeding the repair of bone defects [7,40]. Our study confirmed that acidic conditions do not affect the degradation rate of the Van-PEM hydrogel, which can provide long-term bactericidal action; therefore, it can prevent or improve the local acidic environment and accelerating osteoblast proliferation caused by bacterial infection.
Different concentrations were often used to test the inhibitory effect of the hydrogel on bacteria growth. In this experiment, we selected Van-PEM hydrogel with 2 mg vancomycin in 1 mL PEM hydrogel as the experimental sample. We found that vancomycin in Van-PEM hydrogel exhibited a similar release curve, with a larger proportion released at low concentrations (Figure 3e). Since a high concentration (>3 mg/mL) of vancomycin can inhibit cell growth [7], we believe that 2 mg/mL Van-PEM hydrogel possesses a good drug release effect, which can inhibit the growth of surrounding bacteria and can avoid the side effects caused by a high concentration of vancomycin. Of course, in practical application, we can select different concentrations of vancomycin according to the situation of bone and soft tissue and select sensitive antibiotic according to bacterial culture.
3.2 Antibiotic-loaded PEM hydrogel for the long-term bactericidal effect
The antibacterial activities of the PEM and Van-PEM hydrogels were measured using improved OCM (Figure 4). The results showed that compared with PEM hydrogel, the Van-PEM hydrogel demonstrated a clear antibacterial effect on MRSA (0.16 ± 0.058 mm vs 15.06 ± 1.505 mm, p < 0.05, Figure 4a1) and E. faecalis (0.16 ± 0.066 mm vs 18.62 ± 0.589 mm, p < 0.05, Figure 4b1) on the first day. However, as shown in Figure 4c1, when loaded with vancomycin, the bactericidal effect on E. coli was markedly weakened. Therefore, we replaced the vancomycin with amikacin and found that the resulting PEM hydrogel was much more effective against E. coli (0.10 ± 0.01 mm vs 15.36 ± 1.001 mm, p < 0.05).
(a and b) Bacteriostasis of the Van-PEM hydrogel against S. aureus and Enterococcus on days 1, 8, 15, and 22. It was demonstrated that Van-PEM hydrogel was still able to kill gram-positive bacteria on day 22. (c) Bacteriostasis of the Ami-PEM hydrogel against E. coli on days 1, 8, 15, and 22. (d) Bacterioplankton killing abilities of the PEM and Van-PEM hydrogels.
In addition, the Van-PEM hydrogel was immersed in PBS solution that was changed daily. The Van-PEM hydrogel was removed on days 8, 15, and 22 for bacteriostatic zone experiments. The results indicate that the Van-PEM hydrogel exhibited bacteriostatic effects on S. aureus and E. faecalis on days 8, 15, and 22. However, with an increase in time, the antibacterial effect of the Van-PEM hydrogel gradually decreased, and the antibacterial effect on day 22 was significantly weaker than that on the first day (S. aureus: 2.35 ± 0.26 mm vs 15.06 ± 1.505 mm and E. faecalis: 6.12 ± 1.39 mm vs 18.62 ± 0.589 mm, p < 0.05; Figure 4a and b). The PEM hydrogel loaded with amikacin had a similar antibacterial effect on E. coli (Figure 4c), indicating that the PEM hydrogel can provide long-term sustained release of multiple antibiotics, corresponding to the long-term release of vancomycin (Figure 3c and e), and has the potential to carry multiple antibiotics to compensate for the insufficient antibacterial spectrum of a single antibiotic. For example, bone infections caused by open trauma and diabetes often contain gram-positive and gram-negative bacteria [32]. However, PEM hydrogels can only release both drugs simultaneously, and the conditions for the sequential release of controlled-release drugs need to be further explored.
Subsequently, we tested the bacterioplankton-killing performance of PEM and Van-PEM hydrogels using CCM (Figure 4d). The results showed that the number of bacterial colonies on the culture medium of the Van-PEM hydrogel group was significantly lower than that of the PEM hydrogel group. The number of bacterial colonies on the culture medium of the Van-PEM hydrogel group and PEM hydrogel group at 12 h was 1,800 ± 200 and 6.667 ± 3.055, respectively. These results further confirm the antibacterial effect of the Van-PEM hydrogel.
3.3 Biocompatibility of PEM and Van-PEM hydrogels
The cytotoxicity of bone marrow MSCs cultured with PEM and Van-PEM hydrogels was investigated. After 48 h of co-culture, calcein staining showed no significant difference in the number of living cells among the blank, PEM, and Van-PEM hydrogel groups (Figure 5a). ImageJ software was used to evaluate the area of green fluorescence representing living cells in Figure 5a. The results showed that the fluorescence areas in the control, PEM, and Van-PEM hydrogel groups were similar (Figure 5b), confirming that the PEM and Van-PEM hydrogels were not significantly cytotoxic to MSCs.

(a) Calcein staining after co-culture of the PEM and Van-PEM hydrogels with BMSCs. (b) Fluorescence staining areas in (a) calculated using ImageJ software. (c) BMSCs cultured with PEM hydrogel and Van-PEM hydrogel extracts of different concentrations. (d) Hemolysis reactions of PEM and Van-PEM hydrogels. PEM and Van-PEM hydrogels do not cause hemolysis. (e) Absorbance of hemoglobin in the supernatant of (d).
Additionally, the cellular metabolic activity was determined using the CCK-8 assay to analyze the cytotoxicity of the PEM hydrogel and Van-PEM hydrogel immersion solutions. As shown in Figure 5c, the reproduction of cells in the blank group, PEM group, and 25, 50, and 100% Van-PEM hydrogel immersion groups displayed no significant differences on days 1, 3, and 5 (p > 0.05), and the number of cells on day 5 was significantly increased in all groups. Thus, the PEM and Van-PEM hydrogels did not induce significant toxicity in the MSCs. Previous studies have demonstrated that high concentrations of vancomycin have toxic effects on cells [30]. Our results suggest that Van-PEM hydrogel is beneficial for reducing the cytotoxicity of vancomycin.
During the preparation of PEM and Van-PEM hydrogels, Triton X-100, which causes a hemolytic reaction [41], is needed. Therefore, it is necessary to conduct blood compatibility testing on PEM and Van-PEM hydrogels. Suspended human red blood cells were used to detect hemolysis reactions in the PEM and Van-PEM hydrogels. As shown in Figure 5d, dH2O dissolved almost all the red blood cells, producing a red supernatant, whereas there was no detectable red color in the supernatant of the PBS, PEM, and Van-PEM hydrogel groups. The hemolytic activity was further quantified using a UV spectrophotometer (Figure 5e). These results showed that there was almost no hemoglobin in the supernatant of the PEM hydrogel and Van-PEM hydrogel groups, indicating almost no residual chemical reagents in the PEM and Van-PEM hydrogels, which had good blood compatibility.
3.4 Osteogenesis induced by PEM and Van-PEM hydrogels
Osteoblasts can promote bone formation through bone matrix deposition, and ALP can be used as a marker for early mineralization [42]. The osteogenic differentiation of MC3T3-E1 cells on the PEM and Van-PEM hydrogels was evaluated by measuring the ALP activity (Figure 6a). On the day 3, there was no significant difference in ALP activity among the control, PEM, and Van-PEM hydrogel groups. On day 7, compared with the control group, the ALP activity of the PEM hydrogel and Van-PEM hydrogel groups increased significantly. In addition, ALP staining on day 7 showed that the staining depth of the PEM and Van-PEM hydrogel groups was greater than that of the control group (Figure 6b and Figure S1). ALP results confirmed the ability of the Van-PEM hydrogel to promote bone formation.

(a) Secretion of ALP by osteoblasts in the PEM and Van-PEM hydrogels. PEM and Van-PEM hydrogels can promote the secretion of ALP from osteoblasts. (b) ALP staining of osteoblasts cultured in the PEM and Van-PEM hydrogels for 7 days. (c–e) Expression of osteogenic genes Runx2, OSX, and OCN detected by RT-PCR in osteoblasts cultured in PEM and Van-PEM hydrogels for 14 days. Van-PEM hydrogels can significantly promote the expression of OCN.
Additionally, the expression of osteogenic genes, such as Runx2, OSX, and OCN, in MC3T3-E1 cells was determined by RT-PCR after 14 days of co-culture with PEM and Van-PEM hydrogels (Figure 6c–e). The results showed that the PEM and Van-PEM hydrogels could significantly promote gene expression in osteoblasts, especially the OSX and OCN genes. These results suggested that the Van-PEM hydrogel with a 3D structure can promote the expression of ALP and osteogenic genes in osteoblasts. Van-PEM hydrogels can increase the degree of osteogenic differentiation, which is consistent with the finding that fibrin hydrogels can promote osteogenic differentiation of bone marrow MSCs [43]. A possible reason may be that some cytokines (such as osteoprotegerin) in hydrogels derived from the periosteum extracellular matrix inhibit osteoclast activity [44]. Moreover, collagen promotes osteoblast activity [45]. The Van-PEM hydrogel can also promote the expression of osteogenic genes in osteoblasts compared to the PEM hydrogel, suggesting that vancomycin does not influence the osteogenic effect of the PEM hydrogel.
3.5 Antibacterial and osteogenic functions of the Van-PEM hydrogel in vivo
The model preparation for infectious bone defects in rats is shown in Figure 7a. Micro-CT at 1 week postoperatively showed serious irregular bone erosion areas at the edge of the infectious bone defects, indicating that the infectious bone defect model was successfully prepared (Figure 7b). Micro-CT at 5 weeks postoperatively showed that the erosion area of the skull defect edge in the Van-PEM hydrogel-treated group was significantly smaller than that in the control and bacteria-treated groups. The quantitative results demonstrated that the erosion areas of skull defects in the Van-PEM, control, and bacteria-treated groups were 37.42 ± 2.89, 56.36 ± 4.87, and 67.71 ± 7.54%, respectively (Figure 7c). At 9 weeks postoperatively, micro-CT indicated that the Van-PEM hydrogel-treated group possessed significantly more new bone formation than the control or bacteria-treated groups, and the bone regeneration rate (bone mass/total volume in the red circle, BV/TV) was more than 70%. The osteogenic capacity of the bacteria-treated group was slightly lower than that of the control group. Bone regeneration ratios were 52.11 ± 2.41 and 63.51 ± 3.58%, respectively (Figure 7d). The aforementioned results suggest that infection reduces bone-forming ability and that the Van-PEM hydrogel can improve bone-forming ability. The number of bacteria at the infected sites in the blank, bacteria-treated, and Van-PEM hydrogel groups was measured using the diffusion plate method at 5 and 9 weeks after surgery (Figure 7e). The results showed that the number of bacterial colonies in the culture dish of the bacteria-treated group was much higher than that of the control and Van-PEM hydrogel groups.

(a) Gross picture of the infectious skull defect model. (b) Micro-CT image of infection defect model 1 week after surgery. (c) Degree of skull erosion detected by micro-CT at 5 weeks after surgery. (d) Bone regeneration in the skull defect detected by micro-CT at 9 weeks after surgery. (e) Bacterial growth in the skull wounds of the control, bacteria-treated, and Van-PEM groups at 5 and 9 weeks after surgery.
H&E, Giemsa, and Masson’s trichrome staining schemes were used to determine the anti-infection and osteogenic effects of the hydrogels. At week 5, the number of neutrophils in bone tissue in the bacteria-treated and Van-PEM hydrogel-treated groups was greater than that in the control group (Figure 8a), while the number in the Van-PEM hydrogel-treated group decreased significantly at week 9. An increasing trend was observed in the bacteria-treated group (Figure 8b). Giemsa staining was performed to observe bacteria present in the bone tissue. At Week 5, many bacteria were observed in the bacteria-treated group, whereas the number of bacteria in the control and Van-PEM-treated groups was relatively small (red arrow, Figure 8c). At week 9, many bacteria were still found in the bacteria-treated group, whereas the number of bacteria in the Van-PEM-treated group was significantly reduced (red arrow, Figure 8d). Masson’s trichrome staining showed that a large number of new bones were formed in the Van-PEM hydrogel group, most of which were cancellous bones with complete mineralization of collagen (dyed blue), whereas in the blank and bacteria-treated groups, it was mostly unmineralized collagen (Figure 8e and f).

(a and b) H&E staining of the skull wounds in the control, bacteria-treated, and Van-PEM groups at weeks 5 and 9. Van-PEM hydrogel treatment can significantly reduce the inflammatory response. (c and d) Giemsa staining of each group at the same time points. Van-PEM hydrogel can reduce the number of bacteria in the bone defect site. Red arrows indicate bacteria hidden in tissue. (e and f) Masson staining of each group at the same time points. Van-PEM hydrogel treatment promotes collagen formation.
4 Conclusions
We prepared a novel biomaterial with antibacterial and osteogenic properties by physically embedding vancomycin into an acellular perichondrium hydrogel. The Van-PEM hydrogel possesses a three-dimensional structure with high porosity. For in vitro experiments, the sustained release of a variety of antibiotics, long-term bactericidal properties, bone induction, and osteogenesis ability, and good biocompatibility were demonstrated. Finally, it was confirmed that the Van-PEM hydrogel could kill bacteria for a long period and promote the regeneration of bone tissue in infectious skull defects in a rat model. Therefore, Van-PEM hydrogels have broad prospects for the treatment of infectious bone defects.
-
Funding information: This work was supported by the Natural Science Foundation of Zhejiang Province (grants LBY22H180007 and LBY22H270004) and the Medical and Health Science and Technology Plan Project of Zhejiang Province (grants 2020KY990 and 2022KY416).
-
Author contributions: Qi Dong is responsible for the preparation of antibacterial gel and the writing of articles; Sunfang Chen is responsible for the physical characterization of the gel; Jiuqin Zhou is responsible for histological detection; Jingcheng Liu and Yubin Zou are responsible for animal experiments; Jiawei Lin and Jun Yao are responsible for the osteogenic performance experiment of antibacterial gel; Dan Cai is responsible for bacterial experiments; Danhua Tao and Bing Wu are responsible for processing experimental data and assisting in the writing of articles; and Bin Fang is responsible for the design and management of the whole experiment. All authors have accepted responsibility for the entire content of this manuscript and approved its submission.
-
Conflict of interest: The authors state no conflict of interest.
-
Ethical approval: The research related to animals’ use has been complied with all the relevant national regulations and institutional policies for the care and use of animals.
-
Data availability statement: The datasets generated during and/or analyzed during the current study are available from the corresponding author on reasonable request.
References
[1] Wang Y, Jiang H, Deng Z, Jin J, Meng J, Wang J, et al. Comparison of monolateral external fixation and internal fixation for skeletal stabilisation in the management of small tibial bone defects following successful treatment of chronic osteomyelitis. Biomed Res Int. 2017;2017:6250635.10.1155/2017/6250635Search in Google Scholar PubMed PubMed Central
[2] Sun A, Lin X, Xue Z, Huang J, Bai X, Huang L, et al. Facile surface functional polyetheretherketone with antibacterial and immunoregulatory activities for enhanced regeneration toward bacterium-infected bone destruction. Drug Deliv. 2021;28(1):1649–63.10.1080/10717544.2021.1960924Search in Google Scholar PubMed PubMed Central
[3] Korean Society for Chemotherapy, Korean Society of Infectious Diseases, Korean Orthopaedic Association. Clinical guidelines for the antimicrobial treatment of bone and joint infections in Korea. Infect Chemother. 2014;46(2):125–38.10.3947/ic.2014.46.2.125Search in Google Scholar PubMed PubMed Central
[4] Zwingenberger S, Nich C, Valladares RD, Yao Z, Stiehler M, Goodman SB. Recommendations and considerations for the use of biologics in orthopedic surgery. BioDrugs. 2012;26(4):245–56.10.2165/11631680-000000000-00000Search in Google Scholar PubMed PubMed Central
[5] Freischmidt H, Armbruster J, Rothhaas C, Titze N, Guehring T, Nurjadi D, et al. Treatment of infection-related non-unions with bioactive glass-a promising approach or just another method of dead space management? Mater (Basel). 2022;15(5):1697.10.3390/ma15051697Search in Google Scholar PubMed PubMed Central
[6] Goldberg VM, Akhavan S. Biology of bone grafts, in bone regeneration and repair: Biology and clinical applications. In Lieberman JR, Friedlaender GE, editors. Totowa, NJ: Humana Press; 2005. p. 57–65.10.1385/1-59259-863-3:057Search in Google Scholar
[7] Fang B, Qiu P, Xia C, Cai D, Zhao C, Chen Y, et al. Extracellular matrix scaffold crosslinked with vancomycin for multifunctional antibacterial bone infection therapy. Biomaterials. 2021;268:120603.10.1016/j.biomaterials.2020.120603Search in Google Scholar PubMed
[8] Budiatin AS, Gani MA, Samirah, Ardianto C, Raharjanti AM, Septiani I, et al. Bovine hydroxyapatite-based bone scaffold with gentamicin accelerates vascularization and remodeling of bone defect. Int J Biomater. 2021;2021:5560891.10.1155/2021/5560891Search in Google Scholar PubMed PubMed Central
[9] Kojima KE, de Andrade ESFB, Leonhardt MC, de Carvalho VC, de Oliveira PRD, Lima A, et al. Bioactive glass S53P4 to fill-up large cavitary bone defect after acute and chronic osteomyelitis treated with antibiotic-loaded cement beads: A prospective case series with a minimum 2-year follow-up. Injury. 2021;52(Suppl 3):S23–8.10.1016/j.injury.2021.05.030Search in Google Scholar PubMed
[10] Qiu G, Huang M, Liu J, Wang P, Schneider A, Ren K, et al. Antibacterial calcium phosphate cement with human periodontal ligament stem cell-microbeads to enhance bone regeneration and combat infection. J Tissue Eng Regen Med. 2021;15(3):232–43.10.1002/term.3169Search in Google Scholar PubMed
[11] Yuan J, Wang B, Han C, Huang X, Xiao H, Lu X, et al. Nanosized-Ag-doped porous β-tricalcium phosphate for biological applications. Mater Sci Eng C Mater Biol Appl. 2020;114:111037.10.1016/j.msec.2020.111037Search in Google Scholar PubMed
[12] Qiu X, Li S, Li X, Xiao Y, Li S, Fen Q, et al. Experimental study of β-TCP scaffold loaded with VAN/PLGA microspheres in the treatment of infectious bone defects. Colloids Surf B Biointerfaces. 2022;213:112424.10.1016/j.colsurfb.2022.112424Search in Google Scholar PubMed
[13] Zeng Y, Hoque J, Varghese S. Biomaterial-assisted local and systemic delivery of bioactive agents for bone repair. Acta Biomater. 2019;93:152–68.10.1016/j.actbio.2019.01.060Search in Google Scholar PubMed PubMed Central
[14] Liu YZ, Li Y, Yu XB, Liu LN, Zhu ZA, Guo YP. Drug delivery property, bactericidal property and cytocompatibility of magnetic mesoporous bioactive glass. Mater Sci Eng C Mater Biol Appl. 2014;41:196–205.10.1016/j.msec.2014.04.037Search in Google Scholar PubMed
[15] Kargozar S, Montazerian M, Hamzehlou S, Kim HW, Baino F. Mesoporous bioactive glasses: Promising platforms for antibacterial strategies. Acta Biomater. 2018;81:1–19.10.1016/j.actbio.2018.09.052Search in Google Scholar PubMed
[16] Schnürer SM, Gopp U, Kühn KD, Breusch SJ. Bone substitutes. Orthopade. 2003;32(1):2–10.10.1007/s00132-002-0407-9Search in Google Scholar PubMed
[17] Dos Santos DA, de Guzzi Plepis AM, da Conceição Amaro Martins V, Cardoso GBC, Santos AR Jr., Iatecola A, et al. Effects of the combination of low-level laser therapy and anionic polymer membranes on bone repair. Lasers Med Sci. 2020;35(4):813–21.10.1007/s10103-019-02864-8Search in Google Scholar PubMed
[18] Wolf MT, Daly KA, Brennan-Pierce EP, Johnson SA, Carruthers CA, D’Amore A, et al. A hydrogel derived from decellularized dermal extracellular matrix. Biomaterials. 2012;33(29):7028–38.10.1016/j.biomaterials.2012.06.051Search in Google Scholar PubMed PubMed Central
[19] DeQuach JA, Yuan SH, Goldstein LS, Christman KL. Decellularized porcine brain matrix for cell culture and tissue engineering scaffolds. Tissue Eng Part A. 2011;17(21–22):2583–92.10.1089/ten.tea.2010.0724Search in Google Scholar PubMed PubMed Central
[20] Singelyn JM, DeQuach JA, Seif-Naraghi SB, Littlefield RB, Schup-Magoffin PJ, Christman KL. Naturally derived myocardial matrix as an injectable scaffold for cardiac tissue engineering. Biomaterials. 2009;30(29):5409–16.10.1016/j.biomaterials.2009.06.045Search in Google Scholar PubMed PubMed Central
[21] Farnebo S, Woon CY, Schmitt T, Joubert LM, Kim M, Pham H, et al. Design and characterization of an injectable tendon hydrogel: A novel scaffold for guided tissue regeneration in the musculoskeletal system. Tissue Eng Part A. 2014;20(9–10):1550–61.10.1089/ten.tea.2013.0207Search in Google Scholar
[22] Zhang W, Wang N, Yang M, Sun T, Zhang J, Zhao Y, et al. Periosteum and development of the tissue-engineered periosteum for guided bone regeneration. J Orthop Transl. 2022;33:41–54.10.1016/j.jot.2022.01.002Search in Google Scholar PubMed PubMed Central
[23] da Luz Moreira P, Genari SC, Goissis G, Galembeck F, An YH, Santos AR, Jr. Bovine osteoblasts cultured on polyanionic collagen scaffolds: an ultrastructural and immunocytochemical study. J Biomed Mater Res B Appl Biomater. 2013;101(1):18–27.10.1002/jbm.b.32804Search in Google Scholar PubMed
[24] Ren H, Lian X, Niu B, Zhao L, Zhang Q, Huang D, et al. The study of mechanical and drug release properties of the mineralized collagen/polylactic acid scaffold by tuning the crystalline structure of polylactic acid. J Biomater Sci Polym Ed. 2021;32(6):749–62.10.1080/09205063.2020.1866270Search in Google Scholar PubMed
[25] Lin X, Zhao C, Zhu P, Chen J, Yu H, Cai Y, et al. Periosteum extracellular-matrix-mediated acellular mineralization during bone formation. Adv Healthc Mater. 2018;7(4):1700660.10.1002/adhm.201700660Search in Google Scholar PubMed
[26] Chen K, Lin X, Zhang Q, Ni J, Li J, Xiao J, et al. Decellularized periosteum as a potential biologic scaffold for bone tissue engineering. Acta Biomater. 2015;19:46–55.10.1016/j.actbio.2015.02.020Search in Google Scholar PubMed
[27] Zhao L, Zhao J, Tuo Z, Ren G. Repair of long bone defects of large size using a tissue-engineered periosteum in a rabbit model. J Mater Sci Mater Med. 2021;32(9):105.10.1007/s10856-021-06579-7Search in Google Scholar PubMed PubMed Central
[28] Qiu P, Li M, Chen K, Fang B, Chen P, Tang Z, et al. Periosteal matrix-derived hydrogel promotes bone repair through an early immune regulation coupled with enhanced angio- and osteogenesis. Biomaterials. 2020;227:119552.10.1016/j.biomaterials.2019.119552Search in Google Scholar PubMed
[29] Inzana JA, Schwarz EM, Kates SL, Awad HA. Biomaterials approaches to treating implant-associated osteomyelitis. Biomaterials. 2016;81:58–71.10.1016/j.biomaterials.2015.12.012Search in Google Scholar PubMed PubMed Central
[30] Cai D, Chen S, Wu B, Chen J, Tao D, Li Z, et al. Construction of multifunctional porcine acellular dermal matrix hydrogel blended with vancomycin for hemorrhage control, antibacterial action, and tissue repair in infected trauma wounds. Mater Today Bio. 2021;12:100127.10.1016/j.mtbio.2021.100127Search in Google Scholar PubMed PubMed Central
[31] Tabassum S, Ahmad S, Rehman Khan KU, Tabassum F, Khursheed A, Zaman QU, et al. Phytochemical profiling, antioxidant, anti-inflammatory, thrombolytic, hemolytic activity in vitro and in silico potential of Portulacaria afra. Molecules. 2022;27(8):2377.10.3390/molecules27082377Search in Google Scholar PubMed PubMed Central
[32] Rupp M, Bärtl S, Lang S, Walter N, Alt V. Fracture-related infections after intramedullary nailing: Diagnostics and treatment. Unfallchirurg. 2022;125(1):50–8.10.1007/s00113-021-01117-0Search in Google Scholar PubMed
[33] Masood N, Ahmed R, Tariq M, Ahmed Z, Masoud MS, Ali I, et al. Silver nanoparticle impregnated chitosan-PEG hydrogel enhances wound healing in diabetes induced rabbits. Int J Pharm. 2019;559:23–36.10.1016/j.ijpharm.2019.01.019Search in Google Scholar PubMed
[34] Murshed M. Mechanism of bone mineralization. Cold Spring Harb Perspect Med. 2018;8(12):a031229.10.1101/cshperspect.a031229Search in Google Scholar PubMed PubMed Central
[35] Catelas I, Sese N, Wu BM, Dunn JC, Helgerson S, Tawil B. Human mesenchymal stem cell proliferation and osteogenic differentiation in fibrin gels in vitro. Tissue Eng. 2006;12(8):2385–96.10.1089/ten.2006.12.2385Search in Google Scholar PubMed
[36] Wang M, Li H, Yang Y, Yuan K, Zhou F, Liu H, et al. A 3D-bioprinted scaffold with doxycycline-controlled BMP2-expressing cells for inducing bone regeneration and inhibiting bacterial infection. Bioact Mater. 2021;6(5):1318–29.10.1016/j.bioactmat.2020.10.022Search in Google Scholar PubMed PubMed Central
[37] Wu L, Wang Q, Li Y, Yang M, Dong M, He X, et al. A dopamine acrylamide molecule for promoting collagen biomimetic mineralization and regulating crystal growth direction. ACS Appl Mater Interfaces. 2021;13(33):39142–56.10.1021/acsami.1c12412Search in Google Scholar PubMed
[38] Anselme K. Osteoblast adhesion on biomaterials. Biomaterials. 2000;21(7):667–81.10.1016/S0142-9612(99)00242-2Search in Google Scholar
[39] Arciola CR, Campoccia D, Montanaro L. Implant infections: adhesion, biofilm formation and immune evasion. Nat Rev Microbiol. 2018;16(7):397–409.10.1038/s41579-018-0019-ySearch in Google Scholar PubMed
[40] Pearson JJ, Gerken N, Bae C, Lee KB, Satsangi A, McBride S, et al. In vivo hydroxyapatite scaffold performance in infected bone defects. J Biomed Mater Res B Appl Biomater. 2020;108(3):1157–66.10.1002/jbm.b.34466Search in Google Scholar PubMed
[41] Momtahan N, Panahi T, Poornejad N, Stewart MG, Vance BR, Struk JA, et al. Using hemolysis as a novel method for assessment of cytotoxicity and blood compatibility of decellularized heart tissues. ASAIO J. 2016;62(3):340–8.10.1097/MAT.0000000000000373Search in Google Scholar PubMed
[42] Oezel L, Büren C, Scholz AO, Windolf J, Windolf CD. Effect of antibiotic infused calcium sulfate/hydroxyapatite (CAS/HA) insets on implant-associated osteitis in a femur fracture model in mice. PLoS One. 2019;14(3):e0213590.10.1371/journal.pone.0213590Search in Google Scholar PubMed PubMed Central
[43] Hou T, Xu J, Li Q, Feng J, Zen L. In vitro evaluation of a fibrin gel antibiotic delivery system containing mesenchymal stem cells and vancomycin alginate beads for treating bone infections and facilitating bone formation. Tissue Eng Part A. 2008;14(7):1173–82.10.1089/ten.tea.2007.0159Search in Google Scholar PubMed
[44] Cao Z, Jiang D, Yan L, Wu J. In vitro and in vivo osteogenic activity of the novel vancomycin-loaded bone-like hydroxyapatite/poly(amino acid) scaffold. J Biomater Appl. 2016;30(10):1566–77.10.1177/0885328215623735Search in Google Scholar PubMed
[45] Labbaf S, Tsigkou O, Müller KH, Stevens MM, Porter AE, Jones JR. Spherical bioactive glass particles and their interaction with human mesenchymal stem cells in vitro. Biomaterials. 2011;32(4):1010–8.10.1016/j.biomaterials.2010.08.082Search in Google Scholar PubMed
© 2023 the author(s), published by De Gruyter
This work is licensed under the Creative Commons Attribution 4.0 International License.
Articles in the same Issue
- Research Articles
- Preparation of CdS–Ag2S nanocomposites by ultrasound-assisted UV photolysis treatment and its visible light photocatalysis activity
- Significance of nanoparticle radius and inter-particle spacing toward the radiative water-based alumina nanofluid flow over a rotating disk
- Aptamer-based detection of serotonin based on the rapid in situ synthesis of colorimetric gold nanoparticles
- Investigation of the nucleation and growth behavior of Ti2AlC and Ti3AlC nano-precipitates in TiAl alloys
- Dynamic recrystallization behavior and nucleation mechanism of dual-scale SiCp/A356 composites processed by P/M method
- High mechanical performance of 3-aminopropyl triethoxy silane/epoxy cured in a sandwich construction of 3D carbon felts foam and woven basalt fibers
- Applying solution of spray polyurea elastomer in asphalt binder: Feasibility analysis and DSR study based on the MSCR and LAS tests
- Study on the chronic toxicity and carcinogenicity of iron-based bioabsorbable stents
- Influence of microalloying with B on the microstructure and properties of brazed joints with Ag–Cu–Zn–Sn filler metal
- Thermohydraulic performance of thermal system integrated with twisted turbulator inserts using ternary hybrid nanofluids
- Study of mechanical properties of epoxy/graphene and epoxy/halloysite nanocomposites
- Effects of CaO addition on the CuW composite containing micro- and nano-sized tungsten particles synthesized via aluminothermic coupling with silicothermic reduction
- Cu and Al2O3-based hybrid nanofluid flow through a porous cavity
- Design of functional vancomycin-embedded bio-derived extracellular matrix hydrogels for repairing infectious bone defects
- Study on nanocrystalline coating prepared by electro-spraying 316L metal wire and its corrosion performance
- Axial compression performance of CFST columns reinforced by ultra-high-performance nano-concrete under long-term loading
- Tungsten trioxide nanocomposite for conventional soliton and noise-like pulse generation in anomalous dispersion laser cavity
- Microstructure and electrical contact behavior of the nano-yttria-modified Cu-Al2O3/30Mo/3SiC composite
- Melting rheology in thermally stratified graphene-mineral oil reservoir (third-grade nanofluid) with slip condition
- Re-examination of nonlinear vibration and nonlinear bending of porous sandwich cylindrical panels reinforced by graphene platelets
- Parametric simulation of hybrid nanofluid flow consisting of cobalt ferrite nanoparticles with second-order slip and variable viscosity over an extending surface
- Chitosan-capped silver nanoparticles with potent and selective intrinsic activity against the breast cancer cells
- Multi-core/shell SiO2@Al2O3 nanostructures deposited on Ti3AlC2 to enhance high-temperature stability and microwave absorption properties
- Solution-processed Bi2S3/BiVO4/TiO2 ternary heterojunction photoanode with enhanced photoelectrochemical performance
- Electroporation effect of ZnO nanoarrays under low voltage for water disinfection
- NIR-II window absorbing graphene oxide-coated gold nanorods and graphene quantum dot-coupled gold nanorods for photothermal cancer therapy
- Nonlinear three-dimensional stability characteristics of geometrically imperfect nanoshells under axial compression and surface residual stress
- Investigation of different nanoparticles properties on the thermal conductivity and viscosity of nanofluids by molecular dynamics simulation
- Optimized Cu2O-{100} facet for generation of different reactive oxidative species via peroxymonosulfate activation at specific pH values to efficient acetaminophen removal
- Brownian and thermal diffusivity impact due to the Maxwell nanofluid (graphene/engine oil) flow with motile microorganisms and Joule heating
- Appraising the dielectric properties and the effectiveness of electromagnetic shielding of graphene reinforced silicone rubber nanocomposite
- Synthesis of Ag and Cu nanoparticles by plasma discharge in inorganic salt solutions
- Low-cost and large-scale preparation of ultrafine TiO2@C hybrids for high-performance degradation of methyl orange and formaldehyde under visible light
- Utilization of waste glass with natural pozzolan in the production of self-glazed glass-ceramic materials
- Mechanical performance of date palm fiber-reinforced concrete modified with nano-activated carbon
- Melting point of dried gold nanoparticles prepared with ultrasonic spray pyrolysis and lyophilisation
- Graphene nanofibers: A modern approach towards tailored gypsum composites
- Role of localized magnetic field in vortex generation in tri-hybrid nanofluid flow: A numerical approach
- Intelligent computing for the double-diffusive peristaltic rheology of magneto couple stress nanomaterials
- Bioconvection transport of upper convected Maxwell nanoliquid with gyrotactic microorganism, nonlinear thermal radiation, and chemical reaction
- 3D printing of porous Ti6Al4V bone tissue engineering scaffold and surface anodization preparation of nanotubes to enhance its biological property
- Bioinspired ferromagnetic CoFe2O4 nanoparticles: Potential pharmaceutical and medical applications
- Significance of gyrotactic microorganisms on the MHD tangent hyperbolic nanofluid flow across an elastic slender surface: Numerical analysis
- Performance of polycarboxylate superplasticisers in seawater-blended cement: Effect from chemical structure and nano modification
- Entropy minimization of GO–Ag/KO cross-hybrid nanofluid over a convectively heated surface
- Oxygen plasma assisted room temperature bonding for manufacturing SU-8 polymer micro/nanoscale nozzle
- Performance and mechanism of CO2 reduction by DBD-coupled mesoporous SiO2
- Polyarylene ether nitrile dielectric films modified by HNTs@PDA hybrids for high-temperature resistant organic electronics field
- Exploration of generalized two-phase free convection magnetohydrodynamic flow of dusty tetra-hybrid Casson nanofluid between parallel microplates
- Hygrothermal bending analysis of sandwich nanoplates with FG porous core and piezomagnetic faces via nonlocal strain gradient theory
- Design and optimization of a TiO2/RGO-supported epoxy multilayer microwave absorber by the modified local best particle swarm optimization algorithm
- Mechanical properties and frost resistance of recycled brick aggregate concrete modified by nano-SiO2
- Self-template synthesis of hollow flower-like NiCo2O4 nanoparticles as an efficient bifunctional catalyst for oxygen reduction and oxygen evolution in alkaline media
- High-performance wearable flexible strain sensors based on an AgNWs/rGO/TPU electrospun nanofiber film for monitoring human activities
- High-performance lithium–selenium batteries enabled by nitrogen-doped porous carbon from peanut meal
- Investigating effects of Lorentz forces and convective heating on ternary hybrid nanofluid flow over a curved surface using homotopy analysis method
- Exploring the potential of biogenic magnesium oxide nanoparticles for cytotoxicity: In vitro and in silico studies on HCT116 and HT29 cells and DPPH radical scavenging
- Enhanced visible-light-driven photocatalytic degradation of azo dyes by heteroatom-doped nickel tungstate nanoparticles
- A facile method to synthesize nZVI-doped polypyrrole-based carbon nanotube for Ag(i) removal
- Improved osseointegration of dental titanium implants by TiO2 nanotube arrays with self-assembled recombinant IGF-1 in type 2 diabetes mellitus rat model
- Functionalized SWCNTs@Ag–TiO2 nanocomposites induce ROS-mediated apoptosis and autophagy in liver cancer cells
- Triboelectric nanogenerator based on a water droplet spring with a concave spherical surface for harvesting wave energy and detecting pressure
- A mathematical approach for modeling the blood flow containing nanoparticles by employing the Buongiorno’s model
- Molecular dynamics study on dynamic interlayer friction of graphene and its strain effect
- Induction of apoptosis and autophagy via regulation of AKT and JNK mitogen-activated protein kinase pathways in breast cancer cell lines exposed to gold nanoparticles loaded with TNF-α and combined with doxorubicin
- Effect of PVA fibers on durability of nano-SiO2-reinforced cement-based composites subjected to wet-thermal and chloride salt-coupled environment
- Effect of polyvinyl alcohol fibers on mechanical properties of nano-SiO2-reinforced geopolymer composites under a complex environment
- In vitro studies of titanium dioxide nanoparticles modified with glutathione as a potential drug delivery system
- Comparative investigations of Ag/H2O nanofluid and Ag-CuO/H2O hybrid nanofluid with Darcy-Forchheimer flow over a curved surface
- Study on deformation characteristics of multi-pass continuous drawing of micro copper wire based on crystal plasticity finite element method
- Properties of ultra-high-performance self-compacting fiber-reinforced concrete modified with nanomaterials
- Prediction of lap shear strength of GNP and TiO2/epoxy nanocomposite adhesives
- A novel exploration of how localized magnetic field affects vortex generation of trihybrid nanofluids
- Fabrication and physicochemical characterization of copper oxide–pyrrhotite nanocomposites for the cytotoxic effects on HepG2 cells and the mechanism
- Thermal radiative flow of cross nanofluid due to a stretched cylinder containing microorganisms
- In vitro study of the biphasic calcium phosphate/chitosan hybrid biomaterial scaffold fabricated via solvent casting and evaporation technique for bone regeneration
- Insights into the thermal characteristics and dynamics of stagnant blood conveying titanium oxide, alumina, and silver nanoparticles subject to Lorentz force and internal heating over a curved surface
- Effects of nano-SiO2 additives on carbon fiber-reinforced fly ash–slag geopolymer composites performance: Workability, mechanical properties, and microstructure
- Energy bandgap and thermal characteristics of non-Darcian MHD rotating hybridity nanofluid thin film flow: Nanotechnology application
- Green synthesis and characterization of ginger-extract-based oxali-palladium nanoparticles for colorectal cancer: Downregulation of REG4 and apoptosis induction
- Abnormal evolution of resistivity and microstructure of annealed Ag nanoparticles/Ag–Mo films
- Preparation of water-based dextran-coated Fe3O4 magnetic fluid for magnetic hyperthermia
- Statistical investigations and morphological aspects of cross-rheological material suspended in transportation of alumina, silica, titanium, and ethylene glycol via the Galerkin algorithm
- Effect of CNT film interleaves on the flexural properties and strength after impact of CFRP composites
- Self-assembled nanoscale entities: Preparative process optimization, payload release, and enhanced bioavailability of thymoquinone natural product
- Structure–mechanical property relationships of 3D-printed porous polydimethylsiloxane films
- Nonlinear thermal radiation and the slip effect on a 3D bioconvection flow of the Casson nanofluid in a rotating frame via a homotopy analysis mechanism
- Residual mechanical properties of concrete incorporated with nano supplementary cementitious materials exposed to elevated temperature
- Time-independent three-dimensional flow of a water-based hybrid nanofluid past a Riga plate with slips and convective conditions: A homotopic solution
- Lightweight and high-strength polyarylene ether nitrile-based composites for efficient electromagnetic interference shielding
- Review Articles
- Recycling waste sources into nanocomposites of graphene materials: Overview from an energy-focused perspective
- Hybrid nanofiller reinforcement in thermoset and biothermoset applications: A review
- Current state-of-the-art review of nanotechnology-based therapeutics for viral pandemics: Special attention to COVID-19
- Solid lipid nanoparticles for targeted natural and synthetic drugs delivery in high-incidence cancers, and other diseases: Roles of preparation methods, lipid composition, transitional stability, and release profiles in nanocarriers’ development
- Critical review on experimental and theoretical studies of elastic properties of wurtzite-structured ZnO nanowires
- Polyurea micro-/nano-capsule applications in construction industry: A review
- A comprehensive review and clinical guide to molecular and serological diagnostic tests and future development: In vitro diagnostic testing for COVID-19
- Recent advances in electrocatalytic oxidation of 5-hydroxymethylfurfural to 2,5-furandicarboxylic acid: Mechanism, catalyst, coupling system
- Research progress and prospect of silica-based polymer nanofluids in enhanced oil recovery
- Review of the pharmacokinetics of nanodrugs
- Engineered nanoflowers, nanotrees, nanostars, nanodendrites, and nanoleaves for biomedical applications
- Research progress of biopolymers combined with stem cells in the repair of intrauterine adhesions
- Progress in FEM modeling on mechanical and electromechanical properties of carbon nanotube cement-based composites
- Antifouling induced by surface wettability of poly(dimethyl siloxane) and its nanocomposites
- TiO2 aerogel composite high-efficiency photocatalysts for environmental treatment and hydrogen energy production
- Structural properties of alumina surfaces and their roles in the synthesis of environmentally persistent free radicals (EPFRs)
- Nanoparticles for the potential treatment of Alzheimer’s disease: A physiopathological approach
- Current status of synthesis and consolidation strategies for thermo-resistant nanoalloys and their general applications
- Recent research progress on the stimuli-responsive smart membrane: A review
- Dispersion of carbon nanotubes in aqueous cementitious materials: A review
- Applications of DNA tetrahedron nanostructure in cancer diagnosis and anticancer drugs delivery
- Magnetic nanoparticles in 3D-printed scaffolds for biomedical applications
- An overview of the synthesis of silicon carbide–boron carbide composite powders
- Organolead halide perovskites: Synthetic routes, structural features, and their potential in the development of photovoltaic
- Recent advancements in nanotechnology application on wood and bamboo materials: A review
- Application of aptamer-functionalized nanomaterials in molecular imaging of tumors
- Recent progress on corrosion mechanisms of graphene-reinforced metal matrix composites
- Research progress on preparation, modification, and application of phenolic aerogel
- Application of nanomaterials in early diagnosis of cancer
- Plant mediated-green synthesis of zinc oxide nanoparticles: An insight into biomedical applications
- Recent developments in terahertz quantum cascade lasers for practical applications
- Recent progress in dielectric/metal/dielectric electrodes for foldable light-emitting devices
- Nanocoatings for ballistic applications: A review
- A mini-review on MoS2 membrane for water desalination: Recent development and challenges
- Recent updates in nanotechnological advances for wound healing: A narrative review
- Recent advances in DNA nanomaterials for cancer diagnosis and treatment
- Electrochemical micro- and nanobiosensors for in vivo reactive oxygen/nitrogen species measurement in the brain
- Advances in organic–inorganic nanocomposites for cancer imaging and therapy
- Advancements in aluminum matrix composites reinforced with carbides and graphene: A comprehensive review
- Modification effects of nanosilica on asphalt binders: A review
- Decellularized extracellular matrix as a promising biomaterial for musculoskeletal tissue regeneration
- Review of the sol–gel method in preparing nano TiO2 for advanced oxidation process
- Micro/nano manufacturing aircraft surface with anti-icing and deicing performances: An overview
- Cell type-targeting nanoparticles in treating central nervous system diseases: Challenges and hopes
- An overview of hydrogen production from Al-based materials
- A review of application, modification, and prospect of melamine foam
- A review of the performance of fibre-reinforced composite laminates with carbon nanotubes
- Research on AFM tip-related nanofabrication of two-dimensional materials
- Advances in phase change building materials: An overview
- Development of graphene and graphene quantum dots toward biomedical engineering applications: A review
- Nanoremediation approaches for the mitigation of heavy metal contamination in vegetables: An overview
- Photodynamic therapy empowered by nanotechnology for oral and dental science: Progress and perspectives
- Biosynthesis of metal nanoparticles: Bioreduction and biomineralization
- Current diagnostic and therapeutic approaches for severe acute respiratory syndrome coronavirus-2 (SARS-COV-2) and the role of nanomaterial-based theragnosis in combating the pandemic
- Application of two-dimensional black phosphorus material in wound healing
- Special Issue on Advanced Nanomaterials and Composites for Energy Conversion and Storage - Part I
- Helical fluorinated carbon nanotubes/iron(iii) fluoride hybrid with multilevel transportation channels and rich active sites for lithium/fluorinated carbon primary battery
- The progress of cathode materials in aqueous zinc-ion batteries
- Special Issue on Advanced Nanomaterials for Carbon Capture, Environment and Utilization for Energy Sustainability - Part I
- Effect of polypropylene fiber and nano-silica on the compressive strength and frost resistance of recycled brick aggregate concrete
- Mechanochemical design of nanomaterials for catalytic applications with a benign-by-design focus
Articles in the same Issue
- Research Articles
- Preparation of CdS–Ag2S nanocomposites by ultrasound-assisted UV photolysis treatment and its visible light photocatalysis activity
- Significance of nanoparticle radius and inter-particle spacing toward the radiative water-based alumina nanofluid flow over a rotating disk
- Aptamer-based detection of serotonin based on the rapid in situ synthesis of colorimetric gold nanoparticles
- Investigation of the nucleation and growth behavior of Ti2AlC and Ti3AlC nano-precipitates in TiAl alloys
- Dynamic recrystallization behavior and nucleation mechanism of dual-scale SiCp/A356 composites processed by P/M method
- High mechanical performance of 3-aminopropyl triethoxy silane/epoxy cured in a sandwich construction of 3D carbon felts foam and woven basalt fibers
- Applying solution of spray polyurea elastomer in asphalt binder: Feasibility analysis and DSR study based on the MSCR and LAS tests
- Study on the chronic toxicity and carcinogenicity of iron-based bioabsorbable stents
- Influence of microalloying with B on the microstructure and properties of brazed joints with Ag–Cu–Zn–Sn filler metal
- Thermohydraulic performance of thermal system integrated with twisted turbulator inserts using ternary hybrid nanofluids
- Study of mechanical properties of epoxy/graphene and epoxy/halloysite nanocomposites
- Effects of CaO addition on the CuW composite containing micro- and nano-sized tungsten particles synthesized via aluminothermic coupling with silicothermic reduction
- Cu and Al2O3-based hybrid nanofluid flow through a porous cavity
- Design of functional vancomycin-embedded bio-derived extracellular matrix hydrogels for repairing infectious bone defects
- Study on nanocrystalline coating prepared by electro-spraying 316L metal wire and its corrosion performance
- Axial compression performance of CFST columns reinforced by ultra-high-performance nano-concrete under long-term loading
- Tungsten trioxide nanocomposite for conventional soliton and noise-like pulse generation in anomalous dispersion laser cavity
- Microstructure and electrical contact behavior of the nano-yttria-modified Cu-Al2O3/30Mo/3SiC composite
- Melting rheology in thermally stratified graphene-mineral oil reservoir (third-grade nanofluid) with slip condition
- Re-examination of nonlinear vibration and nonlinear bending of porous sandwich cylindrical panels reinforced by graphene platelets
- Parametric simulation of hybrid nanofluid flow consisting of cobalt ferrite nanoparticles with second-order slip and variable viscosity over an extending surface
- Chitosan-capped silver nanoparticles with potent and selective intrinsic activity against the breast cancer cells
- Multi-core/shell SiO2@Al2O3 nanostructures deposited on Ti3AlC2 to enhance high-temperature stability and microwave absorption properties
- Solution-processed Bi2S3/BiVO4/TiO2 ternary heterojunction photoanode with enhanced photoelectrochemical performance
- Electroporation effect of ZnO nanoarrays under low voltage for water disinfection
- NIR-II window absorbing graphene oxide-coated gold nanorods and graphene quantum dot-coupled gold nanorods for photothermal cancer therapy
- Nonlinear three-dimensional stability characteristics of geometrically imperfect nanoshells under axial compression and surface residual stress
- Investigation of different nanoparticles properties on the thermal conductivity and viscosity of nanofluids by molecular dynamics simulation
- Optimized Cu2O-{100} facet for generation of different reactive oxidative species via peroxymonosulfate activation at specific pH values to efficient acetaminophen removal
- Brownian and thermal diffusivity impact due to the Maxwell nanofluid (graphene/engine oil) flow with motile microorganisms and Joule heating
- Appraising the dielectric properties and the effectiveness of electromagnetic shielding of graphene reinforced silicone rubber nanocomposite
- Synthesis of Ag and Cu nanoparticles by plasma discharge in inorganic salt solutions
- Low-cost and large-scale preparation of ultrafine TiO2@C hybrids for high-performance degradation of methyl orange and formaldehyde under visible light
- Utilization of waste glass with natural pozzolan in the production of self-glazed glass-ceramic materials
- Mechanical performance of date palm fiber-reinforced concrete modified with nano-activated carbon
- Melting point of dried gold nanoparticles prepared with ultrasonic spray pyrolysis and lyophilisation
- Graphene nanofibers: A modern approach towards tailored gypsum composites
- Role of localized magnetic field in vortex generation in tri-hybrid nanofluid flow: A numerical approach
- Intelligent computing for the double-diffusive peristaltic rheology of magneto couple stress nanomaterials
- Bioconvection transport of upper convected Maxwell nanoliquid with gyrotactic microorganism, nonlinear thermal radiation, and chemical reaction
- 3D printing of porous Ti6Al4V bone tissue engineering scaffold and surface anodization preparation of nanotubes to enhance its biological property
- Bioinspired ferromagnetic CoFe2O4 nanoparticles: Potential pharmaceutical and medical applications
- Significance of gyrotactic microorganisms on the MHD tangent hyperbolic nanofluid flow across an elastic slender surface: Numerical analysis
- Performance of polycarboxylate superplasticisers in seawater-blended cement: Effect from chemical structure and nano modification
- Entropy minimization of GO–Ag/KO cross-hybrid nanofluid over a convectively heated surface
- Oxygen plasma assisted room temperature bonding for manufacturing SU-8 polymer micro/nanoscale nozzle
- Performance and mechanism of CO2 reduction by DBD-coupled mesoporous SiO2
- Polyarylene ether nitrile dielectric films modified by HNTs@PDA hybrids for high-temperature resistant organic electronics field
- Exploration of generalized two-phase free convection magnetohydrodynamic flow of dusty tetra-hybrid Casson nanofluid between parallel microplates
- Hygrothermal bending analysis of sandwich nanoplates with FG porous core and piezomagnetic faces via nonlocal strain gradient theory
- Design and optimization of a TiO2/RGO-supported epoxy multilayer microwave absorber by the modified local best particle swarm optimization algorithm
- Mechanical properties and frost resistance of recycled brick aggregate concrete modified by nano-SiO2
- Self-template synthesis of hollow flower-like NiCo2O4 nanoparticles as an efficient bifunctional catalyst for oxygen reduction and oxygen evolution in alkaline media
- High-performance wearable flexible strain sensors based on an AgNWs/rGO/TPU electrospun nanofiber film for monitoring human activities
- High-performance lithium–selenium batteries enabled by nitrogen-doped porous carbon from peanut meal
- Investigating effects of Lorentz forces and convective heating on ternary hybrid nanofluid flow over a curved surface using homotopy analysis method
- Exploring the potential of biogenic magnesium oxide nanoparticles for cytotoxicity: In vitro and in silico studies on HCT116 and HT29 cells and DPPH radical scavenging
- Enhanced visible-light-driven photocatalytic degradation of azo dyes by heteroatom-doped nickel tungstate nanoparticles
- A facile method to synthesize nZVI-doped polypyrrole-based carbon nanotube for Ag(i) removal
- Improved osseointegration of dental titanium implants by TiO2 nanotube arrays with self-assembled recombinant IGF-1 in type 2 diabetes mellitus rat model
- Functionalized SWCNTs@Ag–TiO2 nanocomposites induce ROS-mediated apoptosis and autophagy in liver cancer cells
- Triboelectric nanogenerator based on a water droplet spring with a concave spherical surface for harvesting wave energy and detecting pressure
- A mathematical approach for modeling the blood flow containing nanoparticles by employing the Buongiorno’s model
- Molecular dynamics study on dynamic interlayer friction of graphene and its strain effect
- Induction of apoptosis and autophagy via regulation of AKT and JNK mitogen-activated protein kinase pathways in breast cancer cell lines exposed to gold nanoparticles loaded with TNF-α and combined with doxorubicin
- Effect of PVA fibers on durability of nano-SiO2-reinforced cement-based composites subjected to wet-thermal and chloride salt-coupled environment
- Effect of polyvinyl alcohol fibers on mechanical properties of nano-SiO2-reinforced geopolymer composites under a complex environment
- In vitro studies of titanium dioxide nanoparticles modified with glutathione as a potential drug delivery system
- Comparative investigations of Ag/H2O nanofluid and Ag-CuO/H2O hybrid nanofluid with Darcy-Forchheimer flow over a curved surface
- Study on deformation characteristics of multi-pass continuous drawing of micro copper wire based on crystal plasticity finite element method
- Properties of ultra-high-performance self-compacting fiber-reinforced concrete modified with nanomaterials
- Prediction of lap shear strength of GNP and TiO2/epoxy nanocomposite adhesives
- A novel exploration of how localized magnetic field affects vortex generation of trihybrid nanofluids
- Fabrication and physicochemical characterization of copper oxide–pyrrhotite nanocomposites for the cytotoxic effects on HepG2 cells and the mechanism
- Thermal radiative flow of cross nanofluid due to a stretched cylinder containing microorganisms
- In vitro study of the biphasic calcium phosphate/chitosan hybrid biomaterial scaffold fabricated via solvent casting and evaporation technique for bone regeneration
- Insights into the thermal characteristics and dynamics of stagnant blood conveying titanium oxide, alumina, and silver nanoparticles subject to Lorentz force and internal heating over a curved surface
- Effects of nano-SiO2 additives on carbon fiber-reinforced fly ash–slag geopolymer composites performance: Workability, mechanical properties, and microstructure
- Energy bandgap and thermal characteristics of non-Darcian MHD rotating hybridity nanofluid thin film flow: Nanotechnology application
- Green synthesis and characterization of ginger-extract-based oxali-palladium nanoparticles for colorectal cancer: Downregulation of REG4 and apoptosis induction
- Abnormal evolution of resistivity and microstructure of annealed Ag nanoparticles/Ag–Mo films
- Preparation of water-based dextran-coated Fe3O4 magnetic fluid for magnetic hyperthermia
- Statistical investigations and morphological aspects of cross-rheological material suspended in transportation of alumina, silica, titanium, and ethylene glycol via the Galerkin algorithm
- Effect of CNT film interleaves on the flexural properties and strength after impact of CFRP composites
- Self-assembled nanoscale entities: Preparative process optimization, payload release, and enhanced bioavailability of thymoquinone natural product
- Structure–mechanical property relationships of 3D-printed porous polydimethylsiloxane films
- Nonlinear thermal radiation and the slip effect on a 3D bioconvection flow of the Casson nanofluid in a rotating frame via a homotopy analysis mechanism
- Residual mechanical properties of concrete incorporated with nano supplementary cementitious materials exposed to elevated temperature
- Time-independent three-dimensional flow of a water-based hybrid nanofluid past a Riga plate with slips and convective conditions: A homotopic solution
- Lightweight and high-strength polyarylene ether nitrile-based composites for efficient electromagnetic interference shielding
- Review Articles
- Recycling waste sources into nanocomposites of graphene materials: Overview from an energy-focused perspective
- Hybrid nanofiller reinforcement in thermoset and biothermoset applications: A review
- Current state-of-the-art review of nanotechnology-based therapeutics for viral pandemics: Special attention to COVID-19
- Solid lipid nanoparticles for targeted natural and synthetic drugs delivery in high-incidence cancers, and other diseases: Roles of preparation methods, lipid composition, transitional stability, and release profiles in nanocarriers’ development
- Critical review on experimental and theoretical studies of elastic properties of wurtzite-structured ZnO nanowires
- Polyurea micro-/nano-capsule applications in construction industry: A review
- A comprehensive review and clinical guide to molecular and serological diagnostic tests and future development: In vitro diagnostic testing for COVID-19
- Recent advances in electrocatalytic oxidation of 5-hydroxymethylfurfural to 2,5-furandicarboxylic acid: Mechanism, catalyst, coupling system
- Research progress and prospect of silica-based polymer nanofluids in enhanced oil recovery
- Review of the pharmacokinetics of nanodrugs
- Engineered nanoflowers, nanotrees, nanostars, nanodendrites, and nanoleaves for biomedical applications
- Research progress of biopolymers combined with stem cells in the repair of intrauterine adhesions
- Progress in FEM modeling on mechanical and electromechanical properties of carbon nanotube cement-based composites
- Antifouling induced by surface wettability of poly(dimethyl siloxane) and its nanocomposites
- TiO2 aerogel composite high-efficiency photocatalysts for environmental treatment and hydrogen energy production
- Structural properties of alumina surfaces and their roles in the synthesis of environmentally persistent free radicals (EPFRs)
- Nanoparticles for the potential treatment of Alzheimer’s disease: A physiopathological approach
- Current status of synthesis and consolidation strategies for thermo-resistant nanoalloys and their general applications
- Recent research progress on the stimuli-responsive smart membrane: A review
- Dispersion of carbon nanotubes in aqueous cementitious materials: A review
- Applications of DNA tetrahedron nanostructure in cancer diagnosis and anticancer drugs delivery
- Magnetic nanoparticles in 3D-printed scaffolds for biomedical applications
- An overview of the synthesis of silicon carbide–boron carbide composite powders
- Organolead halide perovskites: Synthetic routes, structural features, and their potential in the development of photovoltaic
- Recent advancements in nanotechnology application on wood and bamboo materials: A review
- Application of aptamer-functionalized nanomaterials in molecular imaging of tumors
- Recent progress on corrosion mechanisms of graphene-reinforced metal matrix composites
- Research progress on preparation, modification, and application of phenolic aerogel
- Application of nanomaterials in early diagnosis of cancer
- Plant mediated-green synthesis of zinc oxide nanoparticles: An insight into biomedical applications
- Recent developments in terahertz quantum cascade lasers for practical applications
- Recent progress in dielectric/metal/dielectric electrodes for foldable light-emitting devices
- Nanocoatings for ballistic applications: A review
- A mini-review on MoS2 membrane for water desalination: Recent development and challenges
- Recent updates in nanotechnological advances for wound healing: A narrative review
- Recent advances in DNA nanomaterials for cancer diagnosis and treatment
- Electrochemical micro- and nanobiosensors for in vivo reactive oxygen/nitrogen species measurement in the brain
- Advances in organic–inorganic nanocomposites for cancer imaging and therapy
- Advancements in aluminum matrix composites reinforced with carbides and graphene: A comprehensive review
- Modification effects of nanosilica on asphalt binders: A review
- Decellularized extracellular matrix as a promising biomaterial for musculoskeletal tissue regeneration
- Review of the sol–gel method in preparing nano TiO2 for advanced oxidation process
- Micro/nano manufacturing aircraft surface with anti-icing and deicing performances: An overview
- Cell type-targeting nanoparticles in treating central nervous system diseases: Challenges and hopes
- An overview of hydrogen production from Al-based materials
- A review of application, modification, and prospect of melamine foam
- A review of the performance of fibre-reinforced composite laminates with carbon nanotubes
- Research on AFM tip-related nanofabrication of two-dimensional materials
- Advances in phase change building materials: An overview
- Development of graphene and graphene quantum dots toward biomedical engineering applications: A review
- Nanoremediation approaches for the mitigation of heavy metal contamination in vegetables: An overview
- Photodynamic therapy empowered by nanotechnology for oral and dental science: Progress and perspectives
- Biosynthesis of metal nanoparticles: Bioreduction and biomineralization
- Current diagnostic and therapeutic approaches for severe acute respiratory syndrome coronavirus-2 (SARS-COV-2) and the role of nanomaterial-based theragnosis in combating the pandemic
- Application of two-dimensional black phosphorus material in wound healing
- Special Issue on Advanced Nanomaterials and Composites for Energy Conversion and Storage - Part I
- Helical fluorinated carbon nanotubes/iron(iii) fluoride hybrid with multilevel transportation channels and rich active sites for lithium/fluorinated carbon primary battery
- The progress of cathode materials in aqueous zinc-ion batteries
- Special Issue on Advanced Nanomaterials for Carbon Capture, Environment and Utilization for Energy Sustainability - Part I
- Effect of polypropylene fiber and nano-silica on the compressive strength and frost resistance of recycled brick aggregate concrete
- Mechanochemical design of nanomaterials for catalytic applications with a benign-by-design focus